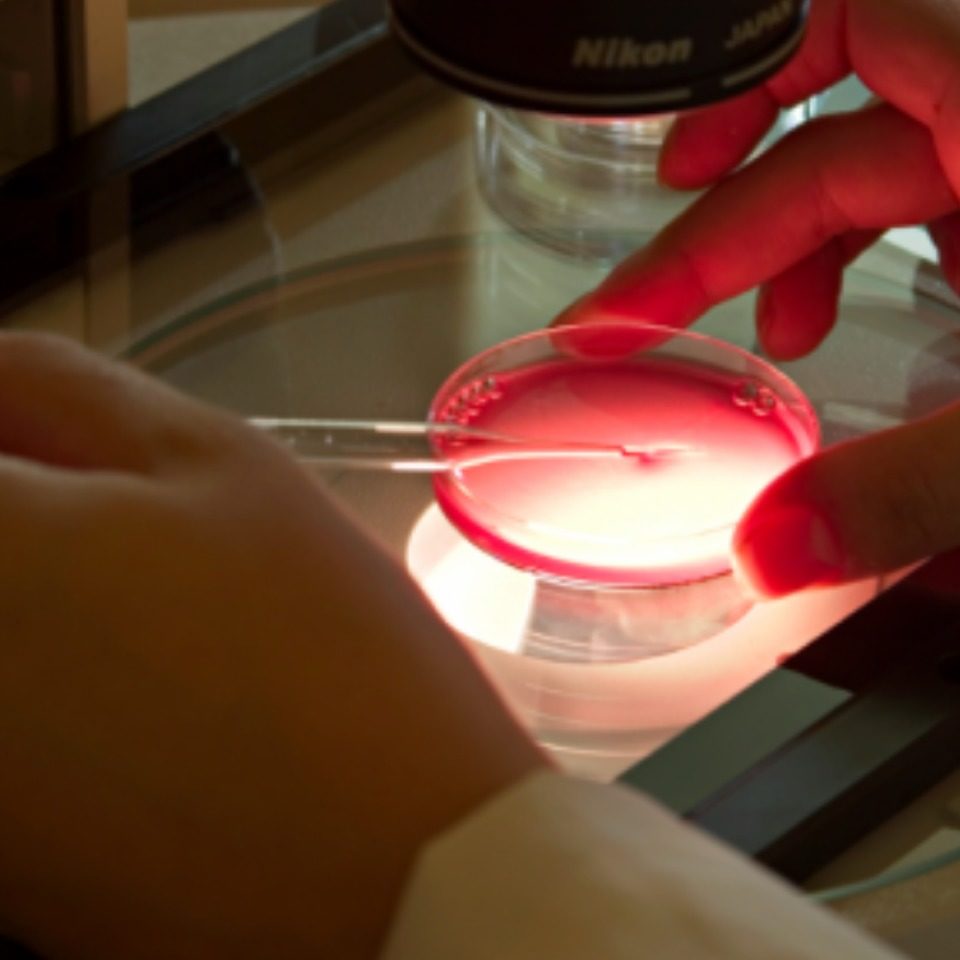

O Projeto Alfa é um dos maiores laboratórios dedicado à medicina reprodutiva no Brasil. Fundado em 2003 por médicos com larga experiência na área de reprodução humana.
Hoje o Alfa conta com um amplo corpo clínico de mais de 50 profissionais e equipamento de última geração para atender com qualidade, segurança e excelência seus pacientes. Em mais de uma década em funcionamento, o Projeto Alfa realiza por ano cerca de 1.500 tratamentos de reprodução.
O Projeto Alfa também tem, desde 2007, o Programa de Educação Continuada, que cuida da formação de seus especialistas nas áreas de reprodução humana e infertilidade conjugal.
Em 2010, O Master em Infertilidade Conjugal adquiriu status de pós-graduação Latu Sensu reconhecida pelo Ministério da Educação (MEC). Dois anos mais tarde, o curso entrou na grade curricular da Faculdade de Ciências Médicas da Santa Casa de São Paulo, uma das escolas de medicina mais importantes do país. O programa já formou mais de 180 médicos e biomédicos.
O Centro Olmos é parceiro do Projeto Alfa (Aliança de Laboratórios de Fertilização Assistida), o mais moderno laboratório de reprodução humana do país.